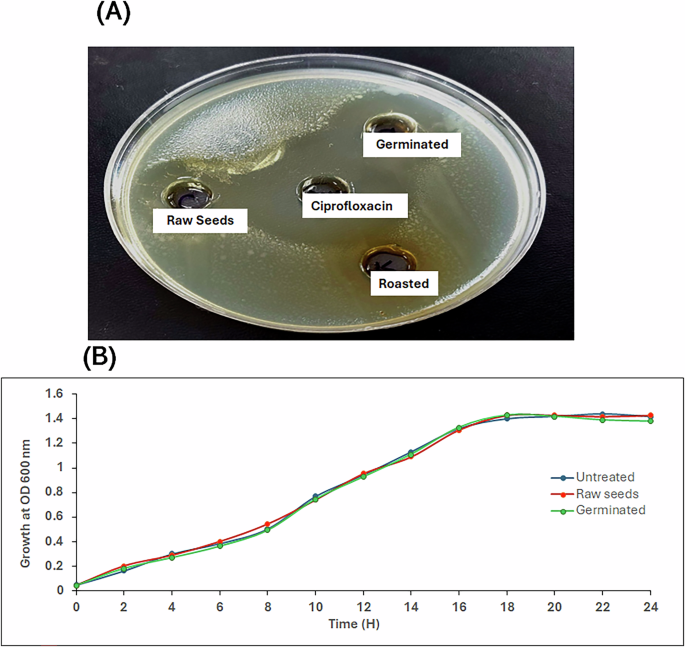
figure 6

Abstract
While mustard seeds offer an enormous wealth of biologically valuable compounds, the obtainable data unveiling the effect of germination and roasting treatments on the metabolic patterns and quorum-sensing (QS) antagonistic effect is limited and demands further investigation. The current study emphasizes proffering a glimpse of the metabolic fluctuations post mustard seeds germination and roasting treatments through UPLC–MS/MS analysis coupled with chemometrics, and its potential entanglements on disrupting the QS system in Pseudomonas aeruginosa PAO1. Correspondingly, 74 chromatographic signals embracing amino acids, phenolic acids, glucosinolates, flavonoids, fatty acids, phospholipids, and terpenoids were chemically characterized. Orthogonal Projection to Latent Structures-Discriminant Analysis (OPLS-DA) models demonstrated perceivable chemical discrepancies among the processed samples, where phenolic acids and flavonoids witnessed a relatively marked rise in germinated and roasted samples compared to raw matches. Nevertheless, aliphatic glucosinolates, primarily sinigrin, glucocheirolin, gluconapin, and progoitrin, along with indole glucosinolates as glucobrassicin, witnessed a moderate elevation with a fold increase (2.5–4.5) in germinated seeds. In contrast, they offered a significant down-regulating tendency following roasting treatment, demonstrating the thermal degradation of glucosinolates into isothiocyanates and canolol. Following germination and roasting treatments, omega-3 fatty acid (linolenic acid and its hydroxylated form) presented a significant upward trend. Most amino acids, primarily serine and tyramine, as well as phospholipids, were continuously diminished throughout the germination and roasting processes. These metabolic shifts were mainly regulated by phenylalanine, tyrosine, and tryptophan biosynthesis, phenylpropanoid biosynthesis, flavonoid biosynthesis, glucosinolate biosynthesis, and glycerophospholipid metabolism pathways. Experimentally speaking, the germinated samples presented the most leading inhibitory effects against pyocyanin production, biofilm formation, twitching, and swarming motility by 75%, 91%, 76%, and 92%, respectively. The OPLS-derived coefficient plot unveiled that the germinated samples were significantly augmented with biologically credited compounds such as syringic acid, syringetin-3-O-glucoside, daidzein, progoitrin, hydroxyglucobrassicin, as well as eicosapentaenoic acid, which might synergistically underlie the QS inhibitory effect. Such integrative work offers meritorious insights into incorporating mustard sprouts and their bioactives in varying nutraceutical and biological applications for circumventing the development of antibiotic resistance.
Similar content being viewed by others
Introduction
In microbial communities, numerous bacterial species are known to possess intricate intracellular and intercellular systems that enable them to interact with their surroundings, communicate with neighbouring cells, and function as multicellular units in a process known as quorum sensing (QS)1. The foundation of QS is bacteria’s capacity to produce autoinducers (AI), which are low molecular weight chemical signalling molecules released to the surroundings in a cell density-dependent manner, leading to virulence, biofilm formation, and food spoilage2. Therefore, efficiently distributing the QS might be a decisive approach to control and stop the expression of foodborne pathogenic bacteria. Rather than eliminating bacteria as conventional sanitisers do, preventing cell-to-cell contact may suppress the expression of specific phenotypes that are less likely to develop microbial resistance2. Undoubtedly, plant sources packed with plentiful bioactive compounds with immense significance may afford a decent choice for QS inhibition, especially since there is a growing disapproval of the usage of chemically produced substances in the food sector1,3. Nowadays, edible seeds are favoured by consumers for their delicious taste, promising nutritional value and represent a prime source of main nutrients, primarily omega-3 fatty acids, vitamins and minerals and accounting for 6% of total protein consumed worldwide4. Among the promising edible seeds fortified with bioactive compounds and increasingly consumed worldwide are mustard seeds.
Mustard seeds (Brassica juncea L.), Brassicaceae family, are widely cultivated and traditionally consumed for edible oil and condiment production as well as sauces, fermented vegetables industries5,6. Mustard seeds, including black, brown/oriental and white/yellow species, were recorded in many Asian countries as traditional food and complementary medicine to manage colds, cough, muscle pain, arthritis, and diabetes7. From a chemical aspect, mustard seeds offer an enormous wealth of chemically and biologically valuable compounds as glucosinolates, phenolic acids, flavonoids, anthocyanins, sterols, omega-3 fatty acids and other sulphur-containing compounds7,8. This phytochemical wealth has been tightly connected with multiple health benefits as antitumor, antimicrobial, anti-viral, antidiabetic, and anti-inflammatory attributes9,10. Even with all these massive pharmacological properties, mustard seeds remain a little-studied drug development resource, though they might merit more investigation for pharmacological uses.
Given the rapid pace of urbanisation and globalisation, different prevailing ways have been introduced and adopted on edible seeds to upgrade the nutritional and functional attributes of seeds via surpassing gut digestibility of balanced macro and micro-nutrients and limiting the bioavailability of anti-nutrients11,12. Germination is among the auspicious green modification approaches increasingly adopted on seeds to fruitfully augment valuable compounds endowed with the biological and health benefits of seeds, pursuing the concept of nutritional therapy13,14. Importantly, germination, also designated as sprouting, is an emerging biological process of material transformation implying different physiological, biochemical, and sensory manipulations concluding with significant improvements in the functional and nutritional profiles of germinated seeds manifested by the enrichment of the vitamins and minerals, as we as bioactive secondary metabolites throughout the course of germination15. On the other hand, roasting is considered one of the most widely utilised pretreatments on edible seeds, which significantly alters the seeds’ microstructure, chemistry, and physical characteristics16. As well, roasting seeds positively affects their colour, flavour, and texture, enhancing the recovery of seed oil nutritional and sensory qualities17. Importantly, previous reports have indicated that conventional oven roasting pretreatments augment the release of bioactive compounds, primarily tocopherols, lignans, and phytosterols in sesame seeds16. Nevertheless, when sesame seeds are improperly roasted, the Maillard reaction can produce dangerous pollutants, including furans and acrylamides, which in turn unfold, degrade, and aggregate proteins as well as cause vitamins to break down negatively affecting the health potential of sesame seeds16. Thus, optimising roasting conditions, such as method, temperature, and duration, seems imperative to maintain the nutritional value, bioactive makeup, and overall quality traits of the consumed seeds.
Despite mustard seeds germination and roasting are widely utilised as pretreatment processing strategies to refine the quality attributes of seeds and satisfy the consumers’ demand18, there are some aspects still to be elucidated including understanding metabolic patterns and their dynamic distribution following mustard seeds germination and roasting with an ultimate scope for boosting the productivity of a diverse array of bioactive compounds and relating health benefits in a resource-efficient manner. Also, identifying the main metabolic pathways linked with these treatments and their entanglements with the biological features has been overlooked until now.
To fill these gaps, the present investigation incorporated Ultra-high Performance Liquid Chromatography and mass spectrometry (UPLC–MS/MS) metabolomics avenue, followed by multivariate data analysis to provide an insightful qualitative and quantitative description of chemical fingerprints—the metabolome—of mustard seeds post exposure to germination and roasting treatments. Coincidentally, understanding the orchestrating metabolic pathways beyond the chemical shifts in the analysed samples was successfully investigated and monitored. Further, to experimentally investigate the impact of germination and roasting on bioactive compounds enrichment with significant potential on QS inhibition, the different seeds were directly subjected to QS inhibitory screening. Complementarily, the efficacy fingerprints that harmoniously combat and interfere with QS pathways were picked out using bioinformatics tools. Worthily, no relevant report has investigated how seed germination and roasting contribute to the chemical profile and function of mustard seeds. Such integrative work successfully summarises the missing links between different treatments and seeds’ chemical changes, metabolic pathways and biological traits, which is promising as an eco-friendly strategy forward for improving the nutraceutical value of mustard seeds worldwide and prolonging the food products’ shelf life.
Results and discussion
Chemical profiling of mustard seeds post-exposure to germination and roasting treatments
The present investigation objectively incorporated UPLC–MS/MS metabolomics avenue to provide an insightful qualitative and quantitative description of chemical fingerprints—the metabolome—of mustard seeds post exposure to germination and roasting treatments.
Correspondingly, 74 chromatographic signals embracing amino acids, phenolic acids, glucosinolates, thiocyanates, flavonoids, fatty acids, phospholipids, terpenoids and phytosterols were chemically characterised. Table 1 uncovered the full list of the chemically profiled compounds distributed among the differently processed mustard seeds, along with their structural details, primarily retention time, parent ions, unique fragment ions, chemical classes and Human Metabolome Database (HMDB) ID. Also, base peak chromatograms (BPCs) in both positive-ion and negative-ion modes of the different mustard samples, raw, germinated and roasted, are laid out in Fig. 1.
Concerning metabolites assignment and following Metabolomics Standards Initiative (MSI) guidelines, 6 signals with numbers 4, 7, 32, 45, 65 and 72 were unambiguously characterised by spectral matching with authentic standards, namely sinigrin, leucine, ferulic acid, kaempferol, linolenic acid and stigmasterol. Further, the remaining compounds were tentatively annotated by spectral comparison of the acquired MS data with our self-established database, referenced spectral databases as Metlin (https://metlin.scripps.edu/auth-login.html) and mzcloud (https://www.mzcloud.org/), as with as relevant literature records.
Notably, using quality control (QC) samples and standard mixing solutions, precision and reproducibility were evaluated to ensure the quality of the generated data.
In a subsequent set of experiments, the calibration curves of the reference standards stated above were utilised to relatively quantify the chemically profiled classes among various mustard samples, where the relative average content of the main chemical classes in the samples under investigation was calculated and expressed as mg Equivalents/g dry extract, as clarified in Fig. S1. Concisely, Fig. 2 presents the ring diagrams simply revealing the dynamic distribution of the main chemical classes among the mustard samples analysed.
Chemical discrimination of the differently processed mustard seeds using multivariate statistical analysis
With the intention of handling the large amount of multifaceted chemical data gained from UPLC–MS analysis. Principal component analysis (PCA), as an unsupervised exploratory approach, was preliminarily applied to offer basic insights into the distribution, variability, and grouping patterns among the examined samples in the PC plot.
The four-component PCA model (Fig. S2) effectively separated the mustard samples into two major clusters over the first two orthogonal PCs, accounting for 78.6% of the total variance and guaranteeing discernible fluctuation in their chemical makeup. For clarity, samples of germinated mustard seeds showed distinct chemical variations, as evidenced by their unambiguous discrimination and grouping on the negative direction of PC1, away from the other samples. Conversely, the close clustering of raw and roasted samples across the positive direction of PC1 gently mirrors propinquity in their chemical profile. Further, PC2 represents the intra-chemical differences between raw and roasted samples as they were oppositely dispersed along the PC2 axis.
Considering this, in order to better understand the noticeable metabolic changes post-germination and roasting treatments, a supervised OPLS-DA model was developed. With a good predictive and discriminant capabilities exemplified by the high test parameters; “R2 (0.984)” and “Q2 (0.971)”, OPLS-DA score plot (Fig. 3A) demonstrated a discernible separation trend among the examined samples where sprouted samples were grouped together well-distinguishing from the others consulting their striking chemical variations established during germination process while the roasted ones were evidently deviated from the raw group along LV2 positive direction confirming their quite compositional discrepancy. In parallel, two clearly distinguishable clusters were shown by the dendrogram of the examined samples (Fig. 3B). The first cluster corresponded to the sprouted samples, while the remaining samples were clustered together in the second one, assuring their chemical heterogeneity. Additionally, the second cluster showed that the chemical profiles of roasted samples differed noticeably from those of raw ones, as shown by their rather distant sub-clustering.
A OPLS-DA score scatter plot of different mustard samples (raw, germinated and roasted). B The respective dendrogram of hierarchical cluster analysis (HCA) by Ward algorithm. C The results of the 20 permutation tests. The OPLS-DA models built in pairwise comparisons of different processing treatments as follows (MS (C) & MS (G) (D) and (MS (C) & MS (R) (F). E, G The respective permutation tests.
Of note, the results of the 20 permutation tests (Fig. 3C) demonstrated that the developed model was not overfit.
In order to comprehend the metabolic pathways primarily associated with the differential metabolites and obtain a thorough understanding of metabolite alterations during germination and roasting treatments, the OPLS-DA models were built in pairwise comparisons of different processing treatments in mustard seeds. As highlighted in Fig. 3D, F, a superior separation was illuminated between raw samples (control) and differently processed groups, as follows (MS (C) & MS (G)) and (MS (C). For all pairwise comparisons in the established OPLS-DA models, the R2Y and Q2 scores were greater than 0.9, demonstrating the practice models’ viability and accuracy. Permutation tests further revealed that the OPLS-DA models did not overfit (Fig. 3E, G).
Metabolite patterns and metabolic pathways associated with germination and roasting treatments of mustard seeds
As alluded to above, different modification approaches, mainly germination and roasting, have been increasingly adopted on edible seeds to upgrade their quality attributes and satisfy the consumers’ demand11.
In light of this investigation, pairwise heatmaps with a colour-coded scale grading from red to green representing the relative content of metabolites from high to low (Fig. 4A, C) as well as the corresponding volcano plots (Fig. 4B, D) were constructed to glimpse the differentially cumulated metabolites fulfilling a threshold of p < 0.05, Variable Importance in Projection (VIP) > 1 and fold change (FC) value > 2 or <0.5.
Pairwise heatmaps with a color-coded scale grading from red to green representing the relative content of metabolites from high to low where (MS (C) & MS (G) (A) and (MS (C) & MS (R) (C). B, D The corresponding volcano plots constructed to glimpse the differentially cumulated metabolites fulfilling a threshold of p < 0.05, VIP > 1 and FC value > 2 or < 0.5 where red dots reflect significant up-regulation while purple ones reflect significant down-regulation of MS (G)/MS (C) or MS (R)/MS (C).
For metabolic pathway enrichment analysis, the putative differential metabolites between the comparison groups were then imported into MetaboAnalyst 6.0 (https://www.metaboanalyst.ca/), supported with the Kyoto Encyclopaedia of Genes and Genomes (KEGG) database.
Collectively, supplemental Tables S1 and S2 fully uncover the key metabolic characteristics among the comparison groups, highlighting VIP, FC, and p-values as well as the metabolic trends and respective regulatory pathways.
Given this, the differential metabolites were congregated into 7 chemical classes, primarily amino acids, glucosinolates, phenolic acid, flavonoids, fatty acids, phospholipids and phytosterols (Tables S1 and S2). An overview of the primary metabolites’ shifts and associated metabolic pathways during mustard seed germination and roasting is given in the next subsections.
Amino acids
As alluded to above, mustard seeds’ high protein content and perfectly balanced amino acid makeup majorly contribute to their nutritional benefits7.
In the current investigation, among the comparison samples, amino acids constituted one of the largest proportions of differential metabolites (Tables S1 and S2). For the sake of clarity, the relative abundance of most amino acids as GABA, serine, tyramine, acetyl tyrosine and glutamyl leucine was continuously diminished throughout the germination and roasting processes (versus the raw (unprocessed) group) inferring that amino acids are broken down and exploited in multiple physiological functions during treatments, such as energy supply required for seedling growth and development, immune modulation and antioxidant potential19. However, phenylalanine and leucine witnessed a noticeable upregulating trend compared with that in raw seeds during the germination process, as they are essential amino acids serving as building blocks of proteins consumed during processing treatments20. Also, this rise is the result of activation of proteolytic enzymes, which break down the stored proteins into their smaller building blocks like phenylalanine and leucine, significantly improving the amino acid profile in the germinated seeds, making it a more nutritious food source20.
Interestingly, this pattern is positively consistent with other lines of data which experimentally demonstrated that germination augments essential amino acids content in brown rice, wheat and pumpkin seeds, while roasting can lead to a remarkable decline in the amino acids content due to the thermal degradation of some amino acids at high temperatures4,21.
In comparing germinated and roasted mustard seeds with raw ones, these differentially expressed amino acids were primarily enriched in the three metabolic pathways, namely phenylalanine, tyrosine and tryptophan biosynthesis, alanine, aspartate and glutamate metabolism, as well as glycine, serine and threonine metabolism (Fig. 5A, B).
Phenolic acids
Mustard seeds offer a powerhouse of valuable antioxidant phenolic compounds with a significant potential in preventing long-term conditions like cancer, heart disease, autoimmune diseases, and neurological diseases5.
As listed in Tables S1 and S2, compared with the unprocessed samples, variations in phenolic acid content post-germination and roasting treatments were discernible. For clarity, a striking accumulation of phenolic acids, mainly syringic acid, coumaric acid, hydroxybenzoic acid, vanillic acid, sinapic acid, chlorogenic acid and salicylic acid-O-hexoxide in the sprouted sample with approximately 6-fold relative increments compared with raw matches (Fig. 4A, C), suggesting that the germination process enhances the release of bound phenolics and activates their biosynthetic pathways. This trend favourably aligns with earlier research that showed that germination significantly raised the seed sprouts’ total phenolic content over time, up to 6.8 times higher than the initial concentration of the corresponding raw ones11,22. In parallel, following roasting treatment, some phenolic acids and their derivatives, mainly hydroxybenzoic acid, vanillic acid, sinapic acid and sinapine, experienced a noticeable increasing trend compared with raw unprocessed samples as roasting might increase the availability of bound phenolic chemicals from the raw seeds by dissolving their cell walls. Notably, these results concur with earlier studies, which experimentally proved that roasting enhances the total phenolic content and antioxidant activities of whole grains, coffee beans, and cashew nuts23,24.
Altogether, as illustrated in Fig. 5, our results indicated that phenylpropanoid biosynthesis is one of the highly changeable metabolic pathways modulated during the germination and roasting process and tightly linked with the notable changes in the overall phenolic content.
Flavonoids
Relatedly, flavonoids and their derivatives represented one of the putatively differential metabolites across the pairwise comparisons in the current work.
Our study mainly demonstrated perturbations in flavonoid biosynthesis, and these changes are primarily reflected in a noticeable difference in the flavonoid content between the sprouted samples and the raw ones. Herein, a marked rise in the relative abundance of different flavonoids namely isorhamnetin, epicatechin, luteolin-O-glycoside, syringetin-O-glucoside, quercetin, daidzein, peonidin-O-glucoside, and kaempferol with a fold change range from 3 to 6 in the germinated group compared with the raw controls was observed signifying the positive impact of germination in augmenting valuable flavonoid compounds endowed with the biological and health benefits of sprouted seeds pursuing the concept of nutritional therapy (Tables S1 and S2). Worth mentioning, these metabolic perturbations in flavonoids and their respective metabolic pathway, flavonoid biosynthesis, came in line with previous records that experimentally proved that germination fruitfully improved flavonoid and lignan accumulation in pumpkin seed sprouts in a time-dependent manner4. Further, another study has pointed out that germination dramatically raised the flavonoid level of red kidney bean sprouts up to 24% compared with raw, ungerminated beans11.
Conversely, no significant variation in the flavonoid content was observed in the roasted samples compared with the germinated and raw ones. Of note, few representative examples of flavonoids, namely isorhamnetin, luteolin-O-glycoside, and syringetin-O-glucoside, showed a notable upward trend throughout the roasting process. Consistent with earlier records, it was found that roasting at 150 °C for 15 min was optimal for maintaining the stability of flavonoid or even enhancing the levels of glycosylated flavonoids in faba leaves25,26.
Glucosinolates
Glucosinolates serve as a large structurally and functionally varied sulphur-containing class of natural products predominantly found in mustard seeds9.
As data shown (Fig. 5), one of the great changeable metabolic pathways perceived in processed mustard seeds was associated with glucosinolate biosynthesis and sulphur metabolism.
In our study, it was observable that the relative contents of glucosinolates moderately increased over the course of mustard seed germination; however, they afforded a significant down-regulation tendency as roasting progressed. In a more specific approach, aliphatic glucosinolates, primarily sinigrin, glucocheirolin, gluconapin, and progoitrin, as well as indole glucosinolates, such as glucobrassicin, witnessed a moderate elevation with a fold increase (2.5–4.5) in germinated seeds compared with the raw ones. While the aromatic glucosinolates were detected in lesser amounts in sprouted samples compared with the raw ones. This slight elevation or even decline of glucosinolates during germination might be due to the enzymatic breakdown (myrosinase) and utilisation of glucosinolates mainly stored in the seeds as a source of energy and nitrogen for the developing seedling during germination27. Further, the dilution effect means that as the seed germinates and the seedling grows, the initial high concentration of glucosinolates in the seed is diluted by the increasing volume of the developing plant tissues. Parallel with a leading study, which dissected that glucosinolate content of Arabidopsis thaliana seeds experienced an initial dramatic decline during the seedling development, followed by a slight elevation upon emergence of the rosette leaves28. These fluctuations in glucosinolate profiles indicated simultaneous functioning of biosynthesis and turnover reactions, with an initial surplus of biosynthesis followed by a period in which turnover outweighs total biosynthesis.
On the other hand, a marked drop of glucosinolates in the roasted samples compared with raw controls was noticed, demonstrating the thermal degradation of glucosinolates during the roasting process into other compounds, including isothiocyanates, nitriles, and others29. These breakdown products, exemplified by allyl isothiocyanate, benzyl isothiocyanate, and canolol, were significantly detected in roasted samples compared with others. Of note, different glucosinolates may degrade at varying rates during roasting, with some being more stable than others. Astonishingly, this degradation is accompanied by the release of different volatile compounds, as nitriles and isothiocyanates majorly contribute to the flavour profile of the roasted food. Worthily, our findings are in good harmony with previously published data29,30.
Fatty acids and their derivatives
In the present investigation, fatty acids, especially unsaturated and hydroxylated forms, were found to be significantly elevated in the roasted and germinated samples and directly implicated in the biosynthesis of the unsaturated fatty acids metabolic pathway. Notably, following germination and roasting treatments, omega-3 fatty acid (linolenic acid and its hydroxylated form) presented a significant upward trend compared with unprocessed samples (Tables S1 and S2). In this investigation, most saturated fatty acids, such as azelaic acid, lauric acid, myristic acid, and eicosenoic acid, were majorly detected in the raw seeds. In the same context, two long-chain saturated fatty acids, such as erucic acid and stearic acid, were found to be overexpressed in the roasted group compared with others. This pattern was in harmony with previously published studies, which showed that the overall fatty acid content decreases during seed germination, which is possibly due to the enzymatic breakdown (lipase) of stored fatty acids and glycerides in a process called beta-oxidation to supply energy and building blocks for new cell structures17. Also, another leading report demonstrated that moderate roasting of almond (Prunus dulcis) kernel oil at 180 °C for 10–20 min increased levels of unsaturated fatty acids (linolenic and elaidic acids) as well as saturated fatty acids (stearic acid)31. However, roasting at a higher temperature (200 °C) for a longer period of time (30 min) may cause fatty acids, particularly unsaturated fatty acids, to break down31.
Equally important, our findings demonstrated that fatty acid glyceride alterations during germination were more significant compared to roasted seeds. This metabolic shift in lipid profile with an increase in linoleoyl and linolenoyl glycerols (specifically mono- or di-acylglycerols) is normal during seed germination, and linked to the breakdown of triacylglycerols, which are the primary storage lipids in seeds, into simpler lipid molecules like monoacylglycerols by lipolytic enzymes such as lipase. This process, principally regulated by the glycerolipid metabolism pathway, provides energy and building blocks for the developing seedling, as well as being involved in membrane repair during germination.
Phospholipids
A number of physiological processes that control plant growth and development, as well as cellular reactions to changes in the environment, are known to be regulated by phospholipids, which are the essential structural elements of plant cell membranes32.
As dissected in Tables S1 and S2, three phospholipid classes, namely lysophosphatidylcholines (lysoPC), phosphatidylethanolamines (PE) and phosphatidylglycerol (PG), were picked out as the differentially modulated lipid species during the germination and roasting processes. These lipid species shared a similar regulatory trend across both processes, where they offered a significant downward shift in their overall content with respect to the raw seeds, demonstrating the membrane phospholipids remodelling and their multifaceted functions in the formation of cell membrane architecture and regulating signalling transduction during embryonic development19. Importantly, water imbibition during germination activates enzymes like phospholipases. These enzymes break down complex phospholipids into simpler molecules, such as free fatty acids and diacylglycerol28.
Further, the heat from roasting can cause the phospholipids to degrade into smaller compounds, such as free fatty acids33. Also, phospholipids often contain polyunsaturated fatty acids (PUFAs), which are highly susceptible to oxidation. The intense heat of roasting accelerates this oxidative degradation, causing the fatty acid tails to break down and form new volatile compounds that contribute to roasted flavour34. Further, Phospholipids that contain an amino group (e.g., phosphatidylethanolamine) can participate in the Maillard reaction, which degrades the phospholipids and influences the flavour profile. Studies on flaxseed and soybeans confirm that phosphatidylethanolamine (PE) is especially vulnerable to degradation via the Maillard reaction during roasting35.
This leads to a net decrease in the overall phospholipid content in roasted seeds. Worthily, these findings matched with previously reported investigations36,37.
In conclusion, KEGG pathway analysis (Fig. 5). revealed that these metabolic shifts were directly linked to the glycerophospholipid metabolism pathway.
Terpenoids and phytosterols
In our investigation, compared with raw seeds, it was apparent that the relative content of phytosterols, such as stigmasterol and desmosterol, was significantly depressed with the seed roasting. However, no significant shift was observed in the germination. Relatedly, a marked drop of carnosic acid in both processed groups compared with raw controls was noted.
Essentially, there was a noticeable decline in beta-tocopherol concentration in roasted samples compared with the others, as tocopherols are susceptible to heat and might be thermally degraded over roasting treatment. This trend matches a previous report that illustrated that the total tocopherol content and the antioxidant capacity exhibit a notable decrease after cocoa beans roasting38.
These metabolic perturbations stated above might be associated with ubiquinone and other terpenoid-quinone biosynthesis pathways, as clarified in Fig. 5.
To sum up, the systematic mapping of the key differential metabolites to their respective metabolic pathways represented the first effort to thoroughly investigate the chemical pattern and the associated regulatory pathway network during mustard seed germination and roasting.
In vitro screening of different mustard samples for microbial growth and quorum-sensing inhibitory activities
Antibacterial screening
All extracts of mustard seeds, raw, germinated and roasted, were screened against P. aeruginosa PAO1. The germinated and control seeds showed prominent antibacterial activity, with inhibition zones of 30 and 26 mm, respectively, compared to 34 mm for the positive control, ciprofloxacin. The remaining samples showed no detectable activity (Fig. 6A).
MIC determination and sub-MIC effects
MIC testing revealed that control and germinated seeds had MICs of 625 and 312 μg/mL, respectively. Growth curve analysis at 312 and 156 μg/mL (½ MIC) for control and germinated seeds, respectively, showed no significant effect on the growth rate of P. aeruginosa PAO1 compared to untreated controls (Fig. 6B).
Evaluation of anti-virulence properties
Pyocyanin inhibition
The control, germinated, and roasted mustard seeds significantly (p ≤ 0.01) reduced pyocyanin production. The germinated seeds exhibited the highest inhibition activity by 75% compared to the contro,l and roasted seeds inhibited by 49 and 30%, respectively (Fig. 7A).
Motility inhibition
The tested mustard extracts caused significant (p ≤ 0.01) reductions in all motility forms of P. aeruginosa PAO1, where the germinated samples exhibited the highest potency among all. The twitching motility was suppressed by 76%, 60%, and 56% by germinating, control, and roasted mustard seeds, respectively. The swimming motility was inhibited by 73%, 57%, and 43% by germinated, control, and roasted mustard seeds, respectively (Fig. 7B). The swarming was reduced by 92%, 72%, and 60% by germinating, control, and roasted mustard seeds, respectively (Fig. 7B).
Biofilm formation inhibition
All seed extracts suppressed biofilm formation significantly (p ≤ 0.01). The germinated seeds showed the highest inhibition activity by 91%. The roasted and control seeds showed less inhibition activity by 41% and 65%, respectively (Fig. 8B).
The above findings collectively indicated the profound impact of germination in enhancing the nutritional and biological qualities of seeds through augmenting the potentially bioactive compounds endowed with the control or prevention of microbial infections through quorum-sensing antagonism prospect. In contrast, roasting negatively affects the functional attributes of mustard seeds through degrading some heat-sensitive bioactive compounds, such as glucosinolates, some flavonoids, vitamins, and omega-3 fatty acids. On the positive side, roasting can enhance flavour and aroma profile due to the Maillard reaction and other chemical changes, as well as potentially improve the digestibility of certain compounds by breaking down some antinutrient barriers39.
Correlation analysis for pinpointing the efficacy constituents beyond quorum-sensing inhibition in the different mustard samples using multivariate analysis
With an intention to facilitate the biological interpretability of the previously examined data, a predictive response model, orthogonal projection to latent structures (OPLS), was implemented to track potential bioactive metabolites that work in concert to mediate the inhibitory mechanisms against quorum sensing.
The OPLS biplot (Fig. 9A), evincing 71.3% of the overall variance, manifestly distinguished among the different mustard samples: raw, germinated, and roasted ones that possessed different QS inhibitory potentials, where germinated samples were all congregated across the positive direction of latent variable 1 (LV1), spatially correlated to the QS inhibitory activity (Y-variables), reinforcing the prior biological observations (refer to Evaluation of anti-virulence properties section). Whilst roasted samples were projected far away, the Y-variables exemplified by pyocyanin, biofilm formation, and motility inhibitory properties that directly reflect ant-QS potential.
Following that, to enhance our biological relevance for the efficacy metabolites that might be beyond the observed QS inhibitory activities, the OPLS-derived coefficient plots were further integrated. Inspection of the OPLS-derived coefficients plot (Fig. 9B) delineated that persuasive bioactive phenolic compounds, mainly syringic acid, sinapic acid, ellagic acid, chlorogenic acid (3-O-Caffeoylquinic acid), peonidin-3-O-glucoside, syringetin-3-O-glucoside, and daidzein, well-praised with their remarkable antimicrobial potential and plentifully existing in the germinated samples, were likely ascribed to the noteworthy QS antagonistic effect. Equally essential, some dominating glucosinolates, namely butyl glucosinolate, progoitrin, hydroxy glucobrassicin, and glucotropaeolin, credited with having a promising antimicrobial action against a vast range of pathogens, might significantly contribute to the observable QS inhibitory potential. Besides this, the relative prevalence of some fatty acids and their derivatives, such as eicosapentaenoic acid, ricinoleic acid, hydroxy linolenic acid, and linoleoyl-glycerol, along with some functional amino acids, particularly leucine and phenylalanine, in raw and sprouted samples might add significant value to the QS antagonism.
Worthily, the gathered findings are consistent with earlier reports uncovering the promising QS inhibitory potential of phenolic acids against foodborne bacterial strains, mainly Salmonella enterica serovar Montevideo and Aeromonas hydrophila40. Relatedly, some compelling evidence has revealed that flavonoids can profoundly disrupt quorum sensing (QS) in certain bacteria via interfering with QS receptors, reducing the production of virulence factors and biofilm formation40. Some leading studies have reported the anti-quorum-sensing activity of fatty acids, particularly unsaturated ones, through potentially reducing bacterial virulence and biofilm formation41.
These bioactive compounds pinpointed above and considerably augmented in mustard sprouts may offer promise as potential chemical candidates for QS antagonism and combating antibiotic resistance.
In summary, inspired by the long-standing use of mustard seeds credited with their nutritive and biological properties as traditional food and complementary medicine, the present work provides an insightful qualitative and quantitative description of chemical fluctuations of mustard seeds post exposure to germination and roasting treatments and their possible QS antagonistic entanglements. The metabolic analysis has figured out that these metabolic shifts among the mustard samples were mainly regulated by phenylalanine, tyrosine and tryptophan biosynthesis, phenylpropanoid biosynthesis, flavonoid biosynthesis, glucosinolate biosynthesis, and glycerophospholipid metabolism pathways. Regarding QS inhibitory screening, the germinated samples augmented with bioactive compounds exhibited the most leading findings exemplified by impeding prominent inhibitory effects against pyocyanin, biofilm formation, twitching, and swarming motility by 75%, 91%, 76%, and 92%, respectively.
Even though our investigation presented promising findings, some limitations in our work should be well-framed. First, a lack of integrative study combining transcriptomics with metabolomics to fully unlock the core regulatory genes orchestrating the metabolic pathways, which in turn govern the chemical alterations during the different processing treatments. Secondly, blocking bacterial QS communication as an effective strategy to make bacteria more vulnerable to antibiotics and the immune system should be expounded on different pathogens, such as Salmonella, Campylobacter, E. coli, and Listeria, to strengthen the biological relevance. Thirdly, a lack of mechanistic studies beyond the QS inhibitory effect of seed extracts from a molecular aspect, dissecting the expression level of the core QS-related genes crucial for QS signalling and regulation in different pathogens. Fourthly, effective analytical platforms merging isolation, purification, functional modification, and mutual efficacy assessment for the biologically active compounds that might underlie the anti-QS potential from mustard sprouts are largely deficient. Undoubtedly, all these limitations should be considerably addressed in future research work to expand the impact of germination and roasting treatments on mustard seeds from chemical and functional standpoints, transforming the edible seeds into a valuable functional food source.
Methods
Chemicals and reagents
Chromatographic grade solvents, including methanol, acetonitrile and formic acid utilised in LC–MS analysis were acquired from Merck, Darmstadt, Germany. The reference standards: sinigrin, leucine, ferulic acid, kaempferol, linolenic acid and stigmasterol were from Sigma-Aldrich (St Louis, MO, USA).
Seeds acquisition and preparation
In June 2023, brown mustard seeds were acquired from the Agricultural Research Centre at Cairo University in Egypt. A batch of uniformly sized seeds (150 g), were carefully cleaned and surface disinfected for 5 min using a 0.5% sodium hypochlorite solution and then thoroughly washed with distilled water to remove disinfectant residues. Next, the mustard seeds batch was equally divided into three portions, where the first portion was directly powdered with an electric blender, labelled with MS (C) (control mustard seeds) and stored at 4 °C prior to extraction. The second fraction was subjected to 10-day germination treatment following4 protocol with minor amendments. In summary, 50 g of seeds were placed on filter paper sheets in a biochemical container. The seeds were left in darkness at 25 ± 2 °C and 60% relative humidity to germinate. Using a mist generator, sterile water was sprayed twice a day to keep the seeds moist. After that, the sprouted seeds were lyophilised, powdered, sieved through a 0.5-mm mesh, labelled with MS (G) (germinated mustard seeds) and kept at 4 °C until further analysis.
The remaining set (50 g) was subjected to controlled roasting treatment following a previous protocol described by us with minor changes16. For roasting treatment, mustard seeds were spread out in uniform thin layers (2–3 mm thick) on 25 × 25 cm trays that had been preheated and placed in a preheated conventional oven (Nüve FNO55, Ankara, Turkey) at 180 °C for 10 min. Afterwards, the roasted seeds are allowed to cool in desiccators at room temperature for 1 h. The seeds were then powdered, sieved through a 0.5-mm mesh, labelled with MS (R) (roasted mustard seeds) and stored at 4 °C until further use.
Extraction of differently treated mustard seeds
Next, the resulting portions of mustard seeds differently treated as illustrated above were submitted to the extraction process, aligning with our previously optimised methods42,43. Briefly, in an ultrasonic bath apparatus (3 L Alpha Plus, Japan), 50 grams of each resultant fraction were extracted twice separately in 200 mL of 70% ethanol at 40 °C for 60 min. The samples’ extracts were vacuum evaporated using a rotary evaporator (Buchi Rotavapor, Switzerland) until dryness. Five independent replicates of each treatment were used for further investigation.
Phytochemical analysis of different mustard extracts using UPLC–QqQ–MS/MS
Chemical profiling of mustard seeds/sprouts extracts post exposure to different priming treatments was conducted using Shimadzu 8045 UPLC triple quadruple (QqQ) apparatus (Shimadzu corporation, Kyoto, Japan) integrated with an electrospray ionisation (ESI) source.
Under the guidance of ref. 11 protocol, a detailed description of chromatographic conditions, the operational parameters for ESI interface and mass data processing parameters was provided in the supplementary material.
Crucially, a detailed description of standard solutions preparation for UPLC–MS relative quantification and method validation has been assigned in the supplementary material, where the analytical parameters, including linearity, limit of detection (LOD), and limit of quantification (LOQ) were based on International Council for Harmonisation (ICH) criteria for analytical validation as complied in Table S3.
Multivariate analysis of the UPLC–MS data and pathway enrichment analysis
Herein, the gathered raw UPLC–MS data were uploaded onto SIMCA-P software (version 14.1; Umetrics, Umea, Sweden) for chemometric analysis. Data overview tool, Principal Component Analysis (PCA), was preliminarily inserted for giving an overview mapping of the collinear dataset, revealing clusters, outliers and trends in the data. Complementarily, Orthogonal Projection to Latent Structures-Discriminant Analysis (OPLS-DA) was incorporated as a superior classification attempt to maximally illuminate confounding variations among the comparable mustard samples, steadily pinpointing metabolic signatures post germination and roasting treatments of mustard seeds. With a scope to catch differential metabolites post exposure to germination and roasting processes, OPLS-DA models and the respective volcano plots were conducted as a pairwise modelling approach between different treated seeds versus control (untreated) ones as follows; the pairwise comparisons were (MS (C) & MS (G)) and (MS (C) & MS (R)). The metabolites’ contributions to the change rates of Y-variables in OPLS-DA were characterised using variable importance of projection (VIP) values, where VIP > 1 suggested the notable dedication of these metabolites to group classifications. Furthermore, a one-way analysis of variance (ANOVA) followed by Tukey’s multiple range test was used to determine the statistical significance between concentration means at the different treatments, with a significance cutoff of p < 0.05 and fold-changes (FC) > 2.0 (or <0.5). Therefore, the compounds that satisfied the requirements of VIP > 1, FC > 2.0 (or <0.5), and p-values < 0.05 were ultimately selected as “differential metabolites.” Of note, the corresponding R2 and Q2 were used to evaluate the models’ prediction reliability.
MetaboAnalyst 6.0 (https://www.metaboanalyst.ca/) was exploited to analyse the different metabolites in each of the pairwise groups, where the heatmaps and respective volcano plots among the comparison samples were constructed. The Kyoto Encyclopaedia of Genes and Genomes (KEGG) database (https://www.metaboanalyst.ca/), plugged into MetaboAnalyst 6.0 software, was chosen for metabolic pathway enrichment analysis, where the metabolic pathway was considered to be significantly enriched if its impact value was greater than 0.1 and its p-value was less than 0.05.
Evaluation of QS inhibitory activity of different mustard extracts
Preliminary antimicrobial screening
The different extracts of mustard seeds, control, germinated, and roasted, were initially screened for antimicrobial activity against Pseudomonas aeruginosa PAO1 using the well-diffusion method44,45. Ciprofloxacin served as the positive control. Each extract was dissolved in 20% (v/v) DMSO at a concentration of 5 mg/mL, and 50 μL was dispensed into 10 mm wells on Luria-Bertani (LB) agar plates. The diameter of the inhibition zones was measured to assess antibacterial activity.
Minimum inhibitory concentration (MIC) and sub-MIC effects
The extracts exhibiting antimicrobial activity were further evaluated to determine their minimum inhibitory concentration (MIC) using the broth microdilution assay in a 96-well plate according to CLSI guidelines46. A volume of 100 μL of Mueller-Hinton broth was dispensed into each well, followed by the addition of 100 μL of each compound. Serial two-fold dilutions (ranging from 2500 to 5 μg/mL) were prepared. Each well was inoculated with P. aeruginosa PAO1 at ~5 × 10⁵ CFU/mL. Controls included untreated bacteria (positive) and media only (negative). Plates were incubated at 37 °C for 24 h, and the MIC was defined as the lowest concentration with no visible growth. Sub-inhibitory concentrations (sub-MICs) were also determined for subsequent analysis47.
Growth curve analysis
The impact of sub-MICs of control and germinated seed extracts at ½ MIC on the growth of P. aeruginosa PAO1 was evaluated. Overnight cultures were inoculated into 100 mL of LB broth, treated with the test compounds, or left untreated, and incubated at 37 °C. Bacterial growth was monitored at 2-h intervals by measuring optical density at OD60048.
Anti-virulence activity
The effect of the different extracts of mustard seeds, control, germinating, and roasted, was evaluated on virulence traits of P. aeruginosa PAO1, including biofilm formation, pyocyanin production, and motility. Control and germinating seed extracts were evaluated at ½ MIC. All assays were conducted in triplicate using culture supernatants49.
Pyocyanin quantification
Pyocyanin production was measured after culturing P. aeruginosa PAO1 in King’s A broth (2% peptone, 1% K₂SO₄, 0.14% MgCl₂) at 150 rpm for 48 h. Pyocyanin was extracted as described by ref. 50, and concentrations (μg/mL) were determined by measuring absorbance at OD520 and applying the factor OD520 × 17.072.
Motility assays
To assess twitching, swarming, and swimming motility, overnight cultures were diluted to an OD600 of 0.1–0.2. For twitching, 2 μL of the culture was stab-inoculated into 1% LB agar plates with or without compounds and incubated at 37 °C for 48 h. Zone diameters were recorded51. Swimming motility was assessed on agar plates containing 1% tryptone, 0.5% NaCl, and 0.5% agar. Treated and untreated plates were inoculated with 2 μL and incubated at 37 °C for 18 h51,52. Swarming motility was tested on agar plates containing 0.5% peptone, 0.2% yeast extract, 1.0% glucose, and 0.5% agar53. Plates were inoculated with 2 μL of the diluted PAO1 culture and incubated at 37 °C for 16 h54. All motility assays were conducted in triplicate using both treated and untreated samples.
Biofilm inhibition assay
Biofilm formation was quantified using the crystal violet staining method55. Overnight cultures were diluted and incubated in 96-well microtiter plates containing LB with or without the test compounds for 24 h at 37 °C. After incubation, non-adherent cells were removed, and the wells were gently washed with 0.9% NaCl. The adherent biofilm was fixed with 99% methanol, stained with 0.5% (w/v) crystal violet, washed, and air-dried. The bound dye was solubilized in 33% (v/v) glacial acetic acid, and absorbance was measured at OD492. All tests were performed in triplicate56.
Efficacy-directed discrimination of the different mustard extracts and bioactives discovery using OPLS analysis
Following that, the orthogonal projection to latent structures (OPLS) model was incorporated as a biologically relevant classification model to glimpse the principal biologically active compounds that might underlie the observable QS inhibitory activity of the different investigated mustard extracts. Notably, R2 cum and Q2 cum were used to evaluate the quality of the established models, where excellent models had values near 1.
Statistical analysis
Data were analysed using Excel’s Data Analysis Toolpak. Means and standard deviations were calculated, and statistical significance was evaluated using Welch’s t-test with thresholds set at *p ≤ 0.05 and **p ≤ 0.01. Each value represents the mean of three independent replicates.
Data availability
Data will be made available on request.
References
Lang, X., Lan, W., Liu, S. & Sun, X. Quorum sensing inhibitory of plant extracts on specific spoilage organisms and the potential utilization on the preservation of aquatic products. Chem. Eng. J. 160259 (2025).
Machado, I., Silva, L. R., Giaouris, E. D., Melo, L. F. & Simões, M. Quorum sensing in food spoilage and natural-based strategies for its inhibition. Food Res. Int. 127, 108754 (2020).
Ghallab, D., Shawky, E., Mohyeldin, M., Metwally, A. M. & Ibrahim, R. S. Propolis: an update on its chemical diversity, botanical origin and biological activities. J. Adv. Pharm. Sci. 2, 76–99 (2025).
Ghallab, D. S. & Ghareeb, D. A. UPLC-MS/MS-based metabolomics and chemometrics unveil metabolic patterns and their regulatory pathways over the course of pumpkin seeds (Cucurbita maxima) germination. Sci. Hortic. 337, 113563 (2024).
Grygier, A. Mustard seeds as a bioactive component of food. Food Rev. Int. 39, 4088–4101 (2023).
Thakur, A. K., Parmar, N., Singh, K. H. & Nanjundan, J. Current achievements and future prospects of genetic engineering in Indian mustard (Brassica juncea L. Czern & Coss.). Planta 252, 56 (2020).
Rahman, M., Khatun, A., Liu, L. & Barkla, B. J. Brassicaceae mustards: phytochemical constituents, pharmacological effects, and mechanisms of action against human disease. Int. J. Mol. Sci. 25, 9039 (2024).
Lietzow, J. Biologically active compounds in mustard seeds: a toxicological perspective. Foods 10, 2089 (2021).
Akhtar, M. J. & Khan, S. A. Chemistry and biological activity of mustard oil: therapeutic benefits and risk to healthcare. Rev. Bras. Farmacogn. 34, 65–79 (2024).
Tian, Y. & Deng, F. Phytochemistry and biological activity of mustard (Brassica juncea): a review. Cyta-J. Food 18, 704–718 (2020).
Ghallab, D. S., Ghareeb, D. A. & Goda, D. A. Integrative metabolomics and chemometrics depict the metabolic alterations of differently processed red kidney beans (Phaseolus vulgaris L.) and in relation to in-vitro anti-diabetic efficacy. Food Res. Int. 192, 114786 (2024).
Soni, K., Samtiya, M., Krishnan, V. & Dhewa, T. in Conceptualizing Plant-Based Nutrition: Bioresources, Nutrients Repertoire and Bioavailability. 157–179 (Springer, 2022).
Kim, H.-J., Han, J.-A., Lim, S.-T. & Cho, D.-H. Effects of germination and roasting on physicochemical and sensory characteristics of brown rice for tea infusion. Food Chem. 350, 129240 (2021).
Yang, G. et al. Development of potential processing technologies for germinated edible seeds and their applications in food: a comprehensive review. Crit. Rev. Food Sci. Nutr. 1–32 (2025).
Aloo, S.-O., Ofosu, F.-K. & Oh, D.-H. Effect of germination on alfalfa and buckwheat: phytochemical profiling by UHPLC-ESI-QTOF-MS/MS, bioactive compounds, and in-vitro studies of their diabetes and obesity-related functions. Antioxidants 10, 1613 (2021).
Ahmed, I. A. M. et al. Effect of conventional oven roasting treatment on the physicochemical quality attributes of sesame seeds obtained from different locations. Food Chem. 338, 128109 (2021).
Thepthanee, C., Li, H., Wei, H., Prakitchaiwattana, C. & Siriamornpun, S. Effect of soaking, germination, and roasting on phenolic composition, antioxidant activities, and fatty acid profile of sunflower (Helianthus annuus L.) seeds. Horticulturae 10, 387 (2024).
Özcan, M. M. et al. White mustard (Sinapis alba L.) seeds: the role of oven and microwave roasting on their bioactive components, antioxidant potential, fatty acids and mineral contents. Eur. Food Res. Technol. 250, 1563–1572 (2024).
Dong, Y. et al. Differential metabolic networks in three energy substances of flaxseed (Linum usitatissimum L.) during germination. Food Chem. 443, 138463 (2024).
Gunathunga, C. et al. Germination effects on nutritional quality: a comprehensive review of selected cereals and pulses changes. J. Food Compos. Anal. 128, 106024 (2024).
Zhou, Q., Geng, F., Deng, Q., Huang, F. & Wang, J. Dynamic analysis of polar metabolites and volatile compounds in sesame seeds during roasting. Cereal Chem. 96, 358–369 (2019).
Dueñas, M., Martínez-Villaluenga, C., Limón, R. I., Peñas, E. & Frias, J. Effect of germination and elicitation on phenolic composition and bioactivity of kidney beans. Food Res. Int. 70, 55–63 (2015).
Chandrasekara, N. & Shahidi, F. Effect of roasting on phenolic content and antioxidant activities of whole cashew nuts, kernels, and testa. J. Agric. Food Chem. 59, 5006–5014 (2011).
Chandrasekara, N. & Shahidi, F. Antioxidative potential of cashew phenolics in food and biological model systems as affected by roasting. Food Chem. 129, 1388–1396 (2011).
Duan, S. et al. Thermal dependent effects of roasting on the volatiles, phenolics, and sensory properties of faba leaves (Vicia faba). LWT 215, 117257 (2025).
Zhou, J. et al. Effects of different processing methods on pulses phytochemicals: an overview. Food Rev. Int. 40, 1138–1195 (2024).
Artés–Hernández, F., Miranda-Molina, F. D., Klug, T. V. & Martínez–Hernández, G. B. Enrichment of glucosinolate and carotenoid contents of mustard sprouts by using green elicitors during germination. J. Food Compos. Anal. 110, 104546 (2022).
Petersen, B., Chen, S., Hansen, C., Olsen, C. & Halkier, B. Composition and content of glucosinolates in developing Arabidopsis thaliana. Planta 214, 562–571 (2002).
Jing, B., Guo, R., Wang, M., Zhang, L. & Yu, X. Influence of seed roasting on the quality of glucosinolate content and flavor in virgin rapeseed oil. Lwt 126, 109301 (2020).
Zhang, L., Chen, J., Zhao, X., Wang, Y. & Yu, X. Influence of roasting on the thermal degradation pathway in the glucosinolates of fragrant rapeseed oil: implications to flavour profiles. Food Chem. X 16, 100503 (2022).
Lin, J.-T. et al. Effects of roasting temperature and duration on fatty acid composition, phenolic composition, Maillard reaction degree and antioxidant attribute of almond (Prunus dulcis) kernel. Food Chem. 190, 520–528 (2016).
Calvano, C. D. et al. Analysis of phospholipids, lysophospholipids, and their linked fatty acyl chains in yellow lupin seeds (Lupinus luteus L.) by liquid chromatography and tandem mass spectrometry. Molecules 25, 805 (2020).
Zhang, D., Duan, X. & Sun, H. Phospholipidomics and quantum chemistry calculation unravel the changes in phospholipid molecules of flaxseed oil during roasting. Food Chem. 404, 134579 (2023).
Yoshida, H., Takagi, S., Kajimoto, G. & Yamaguchi, M. Microwave roasting and phospholipids in soybeans (Glycine max. L.) at different moisture contents. J. Am. Oil Chem. Soc. 74, 117–124 (1997).
Zhang, D. et al. Investigation on lipid profile of peanut oil and changes during roasting by lipidomic approach. Lwt 154, 112594 (2022).
Shrestha, K. & De Meulenaer, B. Effect of seed roasting on canolol, tocopherol, and phospholipid contents, Maillard type reactions, and oxidative stability of mustard and rapeseed oils. J. Agric. Food Chem. 62, 5412–5419 (2014).
Lin, Y. et al. Membrane phospholipids remodeling upon imbibition in Brassica napus L. seeds. Biochem. Biophys. Res. Commun. 515, 289–295 (2019).
Żyżelewicz, D., Krysiak, W., Budryn, G., Oracz, J. & Nebesny, E. Tocopherols in cocoa butter obtained from cocoa bean roasted in different forms and under various process parameters. Food Res. Int. 63, 390–399 (2014).
Babiker, E. E. et al. Effect of roasting on antioxidative properties, polyphenol profile and fatty acids composition of hemp (Cannabis sativa L.) seeds. Lwt 139, 110537 (2021).
Santos, C. A., Lima, E. M. F., Franco, B. D. G. M. & Pinto, U. M. Exploring phenolic compounds as quorum sensing inhibitors in foodborne bacteria. Front. Microbiol. 12, 735931 (2021).
Gopalakrishnan, A. V. et al. Role of fatty acids in modulating quorum sensing in Pseudomonas aeruginosa and Chromobacterium violaceum: an integrated experimental and computational analysis. Int. Microbiol. 28, 1–14 (2024).
Ghallab, D. S., Ibrahim, R. S., Ghareeb, D. A. & El Newehy, N. M. Multi-omics for unveiling potential antidiabetic markers from red, green and black mung beans using NIR-UPLC-MS/MS multiplex approach. Sci. Rep. 15, 1–18 (2025).
El-Banna, A. A., Ibrahim, R. S. & Ghallab, D. S. Unlocking hidden biomarkers: Exploring miswak (Salvadora persica L.) potential in tongue squamous cell carcinoma through UPLC-MS/MS and multivariate analysis. South Afr. J. Bot. 180, 497–511 (2025).
Wayne, P. A. Performance Standards for Antimicrobial Susceptibility Testing. (Clinical and Laboratory Standards Institute, 2011).
Balouiri, M., Sadiki, M. & Ibnsouda, S. K. Methods for in vitro evaluating antimicrobial activity: A review. J. Pharm. Anal. 6, 71–79 (2016).
Clinical and Laboratory Standards Institute. Performance Standards for Antimicrobial Susceptibility Testing: 24th Informational Supplement. (CLSI, 2014).
Naga, N. G. et al. Inhibition of Pseudomonas aeruginosa quorum sensing by methyl gallate from Mangifera indica. Sci. Rep. 13, 17942 (2023).
Mohammed, E. Z. et al. Design, synthesis, and molecular dynamic simulations of some novel benzo [d] thiazoles with anti-virulence activity against Pseudomonas aeruginosa. Eur. J. Med. Chem. 279, 116880 (2024).
Naga, N. G. et al. Innovative application of ceftriaxone as a quorum sensing inhibitor in Pseudomonas aeruginosa. Sci. Rep. 15, 5022 (2025).
Essar, D. W., Eberly, L., Hadero, A. & Crawford, I. P. Identification and characterization of genes for a second anthranilate synthase in Pseudomonas aeruginosa: interchangeability of the two anthranilate synthases and evolutionary implications. J. Bacteriol. 172, 884–900 (1990).
Rashid, M. H. & Kornberg, A. Inorganic polyphosphate is needed for swimming, swarming, and twitching motilities of Pseudomonas aeruginosa. Proc. Natl. Acad. Sci. 97, 4885–4890 (2000).
El-Mowafy, S. A., Shaaban, M. I. & Abd El Galil, K. H. Sodium ascorbate as a quorum sensing inhibitor of Pseudomonas aeruginosa. J. Appl. Microbiol. 117, 1388–1399 (2014).
Kinscherf, T. G. & Willis, D. K. Swarming by Pseudomonas syringae B728a requires gacS (lemA) and gacA but not the acyl-homoserine lactone biosynthetic gene ahlI. J. Bacteriol. 181, 4133–4136 (1999).
Krishnan, T., Yin, W.-F. & Chan, K.-G. Inhibition of quorum sensing-controlled virulence factor production in Pseudomonas aeruginosa PAO1 by ayurveda spice clove (Syzygium Aromati cum) bud extract. Sensors 12, 4016–4030 (2012).
Adonizio, A., Leal, S. M. Jr, Ausubel, F. M. & Mathee, K. Attenuation of Pseudomonas aeruginosa virulence by medicinal plants in a Caenorhabditis elegans model system. J. Med. Microbiol. 57, 809–813 (2008).
Naga, N. G., El-Badan, D. E.-S., Rateb, H. S., Ghanem, K. M. & Shaaban, M. I. Quorum sensing inhibiting activity of cefoperazone and its metallic derivatives on pseudomonas aeruginosa. Front. Cell. Infect. Microbiol. 11, 945 (2021).
Song, L., Morrison, J. J., Botting, N. P. & Thornalley, P. J. Analysis of glucosinolates, isothiocyanates, and amine degradation products in vegetable extracts and blood plasma by LC–MS/MS. Anal. Biochem. 347, 234–243 (2005).
Kelley, J. M., Hughes, L. B. & Bridges, S. L. Does gamma-aminobutyric acid (GABA) influence the development of chronic inflammation in rheumatoid arthritis?. J. Neuroinflammation 5, 1–5 (2008).
Zhang, P. et al. Revisiting fragmentation reactions of protonated α-amino acids by high-resolution electrospray ionization tandem mass spectrometry with collision-induced dissociation. Sci. Rep. 9, 1–10 (2019).
Ghallab, D. S. et al. Exploring the anti-inflammatory bioactive metabolites of some marine algae through integration of metabolomics, network pharmacology and molecular docking analyses. Food Biosci. 50, 102091 (2022).
Mohn, T., Cutting, B., Ernst, B. & Hamburger, M. Extraction and analysis of intact glucosinolates—a validated pressurized liquid extraction/liquid chromatography–mass spectrometry protocol for Isatis tinctoria, and qualitative analysis of other cruciferous plants. J. Chromatogr. A 1166, 142–151 (2007).
Kim, H. W. et al. Identification and quantification of glucosinolates in Korean leaf mustard germplasm (Brassica juncea var. integrifolia) by liquid chromatography–electrospray ionization/tandem mass spectrometry. Eur. Food Res. Technol. 242, 1479–1484 (2016).
Hwang, I. M., Park, B., Dang, Y. M., Kim, S.-Y. & Seo, H. Y. Simultaneous direct determination of 15 glucosinolates in eight Brassica species by UHPLC-Q-Orbitrap-MS. Food Chem. 282, 127–133 (2019).
Yu, X., Ma, F., Zhang, L. & Li, P. Extraction and quantification of sulforaphane and indole-3-carbinol from rapeseed tissues using QuEChERS coupled with UHPLC-MS/MS. Molecules 25, 2149 (2020).
Li, Z. et al. Characterization of glucosinolates in 80 broccoli genotypes and different organs using UHPLC-Triple-TOF-MS method. Food Chem. 334, 127519 (2021).
Ghallab, D. S., Nasr, S. A., Ghareeb, D. A. & Abd El Hafez, M. S. M. Cooking and salting impacts on sea cucumber (Holothuria atra) metabolome and their entanglements on anticoagulant potential as revealed by UPLC-QqQ-MS/MS analysis and chemometrics. J. Food Composit. Anal. 137, 106911 (2024).
Mena, P. et al. Phytochemical profiling of flavonoids, phenolic acids, terpenoids, and volatile fraction of a rosemary (Rosmarinus officinalis L.) extract. Molecules 21, 1576 (2016).
Ghallab, D. S., Mohyeldin, M. M., Shawky, E., Metwally, A. M. & Ibrahim, R. S. Chemical profiling of Egyptian propolis and determination of its xanthine oxidase inhibitory properties using UPLC–MS/MS and chemometrics. Lwt 136, 110298 (2021).
Alberti, Á. LC-ESI-MS/MS methods in profiling of flavonoid glycosides and phenolic acids in traditional medicinal plants: Sempervivum tectorum L. and Corylus avellana L. Chem. Environ. Sci. Med. Corpus ID: 28338808 (2014).
Hu, Z. et al. Canolol as a key equivalent for phenolic content quantification in rapeseed oil via Folin-Ciocalteu method. Eur. Food Res. Technol. 251, 1–12 (2025).
Dawczynski, C., Schubert, R. & Jahreis, G. Amino acids, fatty acids, and dietary fibre in edible seaweed products. Food Chem. 103, 891–899 (2007).
Guan, H., Lin, Q., Ma, C., Ju, Z. & Wang, C. Metabolic profiling and pharmacokinetic studies of sinapine thiocyanate by UHPLC-Q/TOF-MS and UHPLC-MS/MS. J. Pharm. Biomed. Anal. 207, 114431 (2022).
Buiarelli, F., Coccioli, F., Merolle, M., Jasionowska, R. & Terracciano, A. Identification of hydroxycinnamic acid–tartaric acid esters in wine by HPLC–tandem mass spectrometry. Food Chem. 123, 827–833 (2010).
Schüller, M., McQuade, T. A.-P., Bergh, M. S.-S., Pedersen-Bjergaard, S. & Øiestad, E. L. Determination of tryptamine analogs in whole blood by 96-well electromembrane extraction and UHPLC-MS/MS. Talanta Open 7, 100171 (2023).
Zhuang, J. et al. Evaluation of astringent taste of green tea through mass spectrometry-based targeted metabolic profiling of polyphenols. Food Chem. 305, 125507 (2020).
Dutschke, J., Suchowski, M. & Pietsch, J. Simultaneous determination of selected catechins and pyrogallol in deer intoxications by HPLC-MS/MS. J. Chromatogr. B 1180, 122886 (2021).
Flamini, R., De Rosso, M. & Bavaresco, L. Study of grape polyphenols by liquid chromatography-high-resolution mass spectrometry (UHPLC/QTOF) and suspect screening analysis. J. Anal. Methods Chem. 2015, 350259 (2015).
Vega, E. N., Fernández-Ruiz, V., Sánchez-Mata, M. C., Cámara, M. & Morales, P. A rapid and simple UHPLC-DAD method for individual anthocyanin analysis: optimization and validation for wild mediterranean berries and fruit samples. Food Anal. Methods 18, 471–486 (2025).
Dugrand, A., et al. Coumarin and furanocoumarin quantitation in citrus peel via ultraperformance liquid chromatography coupled with mass spectrometry (UPLC-MS). J. Agric. Food Chem. 61, 10677–10684 (2013).
Hussain, A. et al. Determination of total phenolic, flavonoid, carotenoid, and mineral contents in peel, flesh, and seeds of pumpkin (Cucurbita maxima). J. Food Process. Preserv. 45, e15542 (2021).
Popova, I. E. & Morra, M. J. Sinigrin and sinalbin quantification in mustard seed using high performance liquid chromatography–time-of-flight mass spectrometry. J. Food Composit. Anal. 35, 120–126 (2014).
Nada, A. A. et al. An integrated strategy for chemical, biological and palynological standardization of bee propolis. Microchem. J. 182, 107923 https://doi.org/10.1016/j.microc.2022.107923 (2022).
Zhao, W. et al. Rapid screening and identification of daidzein metabolites in rats based on UHPLC-LTQ-orbitrap mass spectrometry coupled with data-mining technologies. Molecules 23, 151 (2018).
Li, K. & Wang, W. An optimized and sensitive UHPLC-ESI-Q-TOF/HRMS demonstrated the dynamic profiling of allantoin, N-trans-feruloyl-3-methoxytyramine, and N-p-coumaroyltyramine from portulaca oleracea L. in vivo in rats. J. Sep. Sci. 48, e70055 (2025).
Griffiths, W. J. Tandem mass spectrometry in the study of fatty acids, bile acids, and steroids. Mass Spectrom. Rev. 22, 81–152 (2003).
Farhadi, F., Baradaran Rahimi, V., Mohamadi, N. & Askari, V. R. Effects of rosmarinic acid, carnosic acid, rosmanol, carnosol, and ursolic acid on the pathogenesis of respiratory diseases. BioFactors 49, 478–501 (2023).
Divito, E. B., Davic, A. P., Johnson, M. E. & Cascio, M. Electrospray ionization and collision induced dissociation mass spectrometry of primary fatty acid amides. Anal. Chem. 84, 2388–2394 (2012).
Ibrahim, R. M. et al. Unveiling the functional components and antivirulence activity of mustard leaves using an LC-MS/MS, molecular networking, and multivariate data analysis integrated approach. Food Res. Int. 168, 112742 (2023).
Gowda, S. G. B. et al. Identification of short-chain fatty acid esters of hydroxy fatty acids (SFAHFAs) in a murine model by nontargeted analysis using ultra-high-performance liquid chromatography/linear ion trap quadrupole-Orbitrap mass spectrometry. Rapid Commun. Mass Spectrom. 34, e8831 (2020).
Ray, J., Smith, K. W., Bhaggan, K., Nagy, Z. K. & Stapley, A. G. F. Characterisation of high 1, 3-distearoyl-2-oleoyl-sn-glycerol content stearins produced by acidolysis of high oleic sunflower oil with stearic and palmitic acids. Eur. J. Lipid Sci. Technol. 116, 532–547 (2014).
Ansolin, M., de Souza, P. T., de Almeida Meirelles, A. J. & Batista, E. A. C. Tocopherols and tocotrienols: An adapted methodology by UHPLC/MS without sample pretreatment steps. Food Analytical. Methods 10, 2165–2174 (2017).
Li, X. et al. Extraction and purification of eicosapentaenoic acid and docosahexaenoic acid from microalgae: a critical review. Algal Res. https://doi.org/10.1016/j.algal.2019.101619 (2019).
Choi, G. H. et al. Quantitative analyses of ricinoleic acid and ricinine in Ricinus communis extracts and its biopesticides. J. Appl. Biol. Chem. 59, 165–169 (2016).
Mo, S., Dong, L., Hurst, W. J. & van Breemen, R. B. Quantitative analysis of phytosterols in edible oils using APCI liquid chromatography–tandem mass spectrometry. Lipids 48, 949–956 (2013).
Edpuganti, V. & Mehvar, R. UHPLC–MS/MS analysis of arachidonic acid and 10 of its major cytochrome P450 metabolites as free acids in rat livers: Effects of hepatic ischemia. J. Chromatogr. B 964, 153–163 (2014).
Ghallab, D. S., Shawky, E., Ibrahim, R. S. & Mohyeldin, M. M. Comprehensive metabolomics unveil the discriminatory metabolites of some Mediterranean Sea marine algae in relation to their cytotoxic activities. Sci. Rep. 12, 8094 (2022).
Yang, B., Yang, H., Chen, F., Hua, Y. & Jiang, Y. Phytochemical analyses of Ziziphus jujuba Mill. var. spinosa seed by ultrahigh performance liquid chromatography-tandem mass spectrometry and gas chromatography-mass spectrometry. Analyst 138, 6881–6888 (2013).
Crescenzi, M. A., Cerulli, A., Montoro, P. & Piacente, S. Metabolite profiling for typization of “rucola della piana del sele”(PGI), Eruca sativa, through UHPLC-Q-Exactive-Orbitrap-MS/MS analysis. Foods 12, 3384 (2023).
Funding
Open access funding provided by The Science, Technology & Innovation Funding Authority (STDF) in cooperation with The Egyptian Knowledge Bank (EKB).
Author information
Authors and Affiliations
Contributions
Dina S. Ghallab: conceptualisation, methodology, data curation, Writing—original draft preparation, supervision, validation, writing—reviewing and editing. Mona E. M. Mabrouk: methodology, data curation, supervision, validation, writing–review & editing. Nourhan G. Naga: conceptualisation, methodology, data curation, writing—original draft preparation, supervision, validation, writing—reviewing and editing.
Corresponding author
Ethics declarations
Competing interests
The authors declare no competing interests.
Additional information
Publisher’s note Springer Nature remains neutral with regard to jurisdictional claims in published maps and institutional affiliations.
Supplementary information
Rights and permissions
Open Access This article is licensed under a Creative Commons Attribution 4.0 International License, which permits use, sharing, adaptation, distribution and reproduction in any medium or format, as long as you give appropriate credit to the original author(s) and the source, provide a link to the Creative Commons licence, and indicate if changes were made. The images or other third party material in this article are included in the article’s Creative Commons licence, unless indicated otherwise in a credit line to the material. If material is not included in the article’s Creative Commons licence and your intended use is not permitted by statutory regulation or exceeds the permitted use, you will need to obtain permission directly from the copyright holder. To view a copy of this licence, visit http://creativecommons.org/licenses/by/4.0/.
About this article
Cite this article
Ghallab, D.S., Mabrouk, M.E.M. & Naga, N.G. Comparison of metabolic profiles, regulatory pathways, and quorum sensing inhibition activity of brown mustard seeds (Brassica juncea L.) post germination and roasting treatments. npj Sci Food 9, 221 (2025). https://doi.org/10.1038/s41538-025-00606-5
Received:
Accepted:
Published:
Version of record:
DOI: https://doi.org/10.1038/s41538-025-00606-5